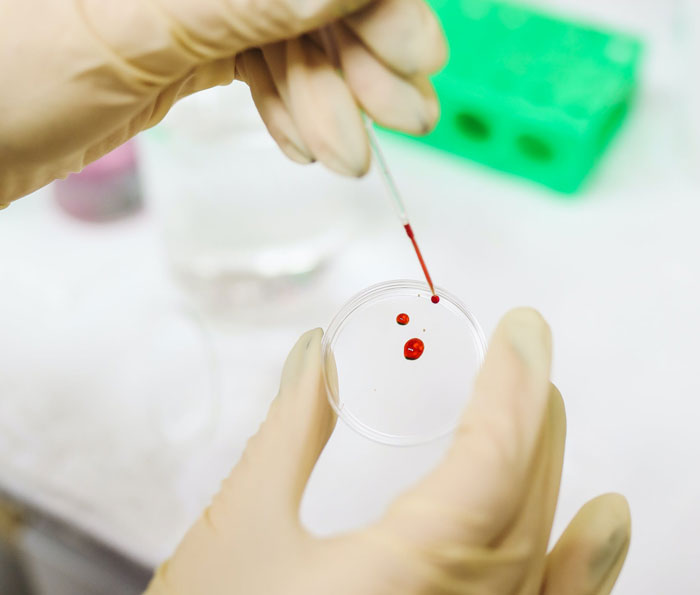
30 False Facts That Are So Ingrained In People’s Minds They Can’t See The Truth, As Shared Online

30 False Facts That Are So Ingrained In People’s Minds They Can’t See The Truth, As Shared Online
Interview With AuthorIt’s very human to get hooked on exciting and shocking things and share that information with others. However, not all that we hear or read is true, no matter how exciting it may seem.
Misinformation can spread like wildfire, even long after being disproven. Luckily, the internet is full of curious people who, seeking to dispel those fake truths, band together in online threads like this and share their knowledge for the world to see. Check out what they wrote down below, and if you feel like you want to keep going, check out this other article of ours, too!
More info: Reddit
This post may include affiliate links.
 Money can’t buy happiness. Complete b******t! Money buys tons of happiness and anyone who says it doesn’t is a liar or doesn’t know how to have a good time!
Money can’t buy happiness. Complete b******t! Money buys tons of happiness and anyone who says it doesn’t is a liar or doesn’t know how to have a good time!
 The lady who sued McDonalds for coffee being too hot was exaggerating and an opportunist. McDonald’s smeared her name. The poor woman needed skin grafts (!!!!) due to that coffee burn.
The lady who sued McDonalds for coffee being too hot was exaggerating and an opportunist. McDonald’s smeared her name. The poor woman needed skin grafts (!!!!) due to that coffee burn.
and she only asked for her medical bill to be covered at first? Some panda hopefully have some good links about this?
Some false facts start as a joke, some are made to deceive, and some are first really thought to be correct, only to be proven otherwise later. But regardless of its origin, if not stopped, this fake or outdated information is, at best, annoying and, at worst, harmful.
As we found out by reaching out to u/Clear-Type5753, that is precisely why they started this thread. “There’s so much misinformation out there, and people often guess or don’t research properly,” says the author, emphasizing just how much misinformation there is around us nowadays.
 People love to talk about how pandas are incapable of surviving, and so evolutionarily incompetent that they need to be goaded into even reproducing.
In fact, pandas are very highly specialized and adapted to an ecological niche that was never under threat until human intervention. They're grazers in bamboo forests, which used to be an enormous biome, and their behavioral issues in captivity are just a result of not having access to even a reasonable approximation of that biome.
They evolved to be picky about food because they evolved surrounded on all sides by food and adapted to extract the best food efficiently, instead of clear-cutting their environment to get worse food. They evolved to patrol enormous territories because they evolved surrounded by endless usable habitat in all directions. It's not their fault that animals act weird when transplanted from their homes.
People love to talk about how pandas are incapable of surviving, and so evolutionarily incompetent that they need to be goaded into even reproducing.
In fact, pandas are very highly specialized and adapted to an ecological niche that was never under threat until human intervention. They're grazers in bamboo forests, which used to be an enormous biome, and their behavioral issues in captivity are just a result of not having access to even a reasonable approximation of that biome.
They evolved to be picky about food because they evolved surrounded on all sides by food and adapted to extract the best food efficiently, instead of clear-cutting their environment to get worse food. They evolved to patrol enormous territories because they evolved surrounded by endless usable habitat in all directions. It's not their fault that animals act weird when transplanted from their homes.
 As a dietitian, it drives me nuts when people say that iceberg lettuce is devoid of nutrition. A typical serving of 100 grams provides 17% of your daily Vitamin A and 20% of your Vitamin K requirements, all for just 14 calories. Plus, it's a good source of potassium, manganese, and fiber. So, it’s far from being “just water.” There's definitely nutritional value there.
As a dietitian, it drives me nuts when people say that iceberg lettuce is devoid of nutrition. A typical serving of 100 grams provides 17% of your daily Vitamin A and 20% of your Vitamin K requirements, all for just 14 calories. Plus, it's a good source of potassium, manganese, and fiber. So, it’s far from being “just water.” There's definitely nutritional value there.
Helping this cause, the OP also added their own contribution to this actively disproven “facts” list. They said that this so-called “truth” would be the belief many people have that a dog’s mouth is cleaner than a human’s. In reality, both humans’ and dogs’ mouths are full of many different species of microbes (at least 600 each), and comparing them is akin to apples and oranges.
The post received around 10,000 upvotes in no more than 2 days, to which the poster said, “I was excited and surprised by the overwhelming response.” In addition to that, being contacted by Bored Panda caught the author unexpectedly. According to them, this surprise was welcomed nonetheless, and they’re happy and honored to have the data of their post used to pursue the further extermination of this misinformation.
 That you can catch a cold from being outside in the cold. You become more susceptible, but the actual cold is a virus you can only catch from other people.
That you can catch a cold from being outside in the cold. You become more susceptible, but the actual cold is a virus you can only catch from other people.
Has anybody in the past 75 years EVER actually thought that a cold was literally caused by being in the cold? When they say they caught a cold from being outside, wasn't that always just a shorthand for "I caught a cold that I otherwise might not have, because being in the cold made me more susceptible"? I've heard people say it, and every single one understands about viruses and knows being in the cold doesn't directly cause a cold.
It’s not like fake news is something fresh and unfamiliar to us. So why do people keep falling for it despite that? This question led us to do more research, coming across an article by the Center for Information Technology & Society.
Surprisingly, gullibility is not to blame here. According to the article, falling prey to misinformation most often happens due to cognitive biases, also known as mental shortcuts and automatic processes meant to make our lives easier, which we all have.
 The whole alpha wolf thing
The whole alpha wolf thing
This study was done on captive wolves, so it was essentially like thinking you are an expert on human behavior because you studied prisoners. In reality, wolf packs are families, and the 'alphas' are the parents. It is their job to keep the other members of the pack protected and well fed and happy. So that guy at the amusement park with the waist pack full of snacks, making sure his kids are safely having fun and everyone is well fed and hydrated? That is the truest alpha male you will ever find.
 Way too many Confederate States of America apologists still out there. The war was over slavery. Not taxes, tariffs, exports, states rights or any of the other tired excuses.
Way too many Confederate States of America apologists still out there. The war was over slavery. Not taxes, tariffs, exports, states rights or any of the other tired excuses.
So, this basically reduces the whole conflict to being the answer to a Trivial Pursuit question. Slavery was indeed a primary reason but for the south it was one more of economics than morality. If slavery had been the sole reason, then the North would have been wise to jet let the South go. Pressure to be recognized as a legitimate sovereign nation, especially by European countries would have eventually led the Confederacy to free the slaves themselves. With that issue no longer standing in the way both sides would have come to the conclusion that they should reunite. The problem with this scenario is that it doesn't take into account other factors such as the North's economic domination of the South and States' rights. Please don't trivialize this terrible chapter in American history by saying it was about one thing and one thing only. That's just an insult to the memories of those that fought and died on both sides of the conflict.
One of the main culprits here is confirmation bias. It causes people to seek, favor, and remember information in a way that would confirm their preexisting beliefs.
However, the list of cognitive biases significantly affecting our information use doesn’t stop here. For instance, we tend to act without fully understanding the information in front of us, reacting to and forming opinions based on the attention-grabbing titles and not reading the article they’re connected to.
 Cracking your knuckles causes arthritis
Cracking your knuckles causes arthritis
If it did cause arthritis, I would suffer in almost every joint in my body.
 That people used to only live to age 30 in the past. I can't believe how often people still mention this misconception. Average mortality rate ≠ individual life expectancy
That people used to only live to age 30 in the past. I can't believe how often people still mention this misconception. Average mortality rate ≠ individual life expectancy
Popularity is another strong factor that causes something known as the “bandwagon effect.” In other words, when people see that a lot of fellow users like and support something, they’re more likely to do it, too.
When we see something shared and reacted to very many times, we might assume that someone else must’ve verified it before for it to get so popular, and thus, we focus way less on assessing this information.
 The misconception that humans only use 10% of their brains, which has been debunked by neuroscience. In reality, various parts of the brain have specific functions, and most of the brain is active at different times.
The misconception that humans only use 10% of their brains, which has been debunked by neuroscience. In reality, various parts of the brain have specific functions, and most of the brain is active at different times.
Sometimes it's not that hard to believe. Trump rally, Andrew Tate and Elon Musk fanboys, NFT investors...
As many could guess, falling for fake news can just as well be accredited to political views and alignments. People are prone to more readily accept information that positively correlates with their political ideology and reject news opposing it.
And lastly, misinformation is notoriously sticky, and it’s difficult to undo the effect that false news leaves. According to the article, our memory is not very good at differentiating between a truth and a lie. When it comes to remembering something, we sometimes tend to assume that information was correct, regardless of whether it was false and whether it was later corrected.
 Myers-Briggs personality test has no indepently verified evidence behind it. It has no more scientific evidence behind it than a Cosmo quiz.
Myers-Briggs personality test has no indepently verified evidence behind it. It has no more scientific evidence behind it than a Cosmo quiz.
It makes a lot more sense when you distinguish between the way corporations are using it and the rather more salient lesson from the Myers Briggs fad that other people have different personalities, needs and preferences than you and you can’t always make assumptions about others based on what YOU prefer.
 Carrots improve your night vision.
It was a “fact” promoted by the Allies during WW2 to hide their invention of radar. All those British pilots are downing German bombers at night because they eat so many carrots! Totally not because we have a device that lets us see them day or night from dozens of miles away.
Carrots improve your night vision.
It was a “fact” promoted by the Allies during WW2 to hide their invention of radar. All those British pilots are downing German bombers at night because they eat so many carrots! Totally not because we have a device that lets us see them day or night from dozens of miles away.
To summarize, in this day and age, information can spread faster than ever before, and disproven “truths” that keep circulating can be more dangerous than they ever were.
Not all of the false information is dangerous - some is simply annoying. But knowing how to differentiate between what’s real and what’s not online is crucial. And updating your mental libraries with corrected facts like the ones we see in this Reddit thread is definitely beneficial.
 "the triptofan in turkey makes you sleepy!"
1: you'd have to eat an entire 20 pound turkey by yourself in one sitting to get enough triptofan to get sleepy from it
2: chicken actually has higher concentrations of it, and nobody is running around saying chicken made them sleepy.
Overeating makes you sleepy. Not the turkey.
"the triptofan in turkey makes you sleepy!"
1: you'd have to eat an entire 20 pound turkey by yourself in one sitting to get enough triptofan to get sleepy from it
2: chicken actually has higher concentrations of it, and nobody is running around saying chicken made them sleepy.
Overeating makes you sleepy. Not the turkey.
Dealing with keeping on a "big happy family" face is always what made me sleepy on Thanksgiving from exhausting my social battery, but blaming the turkey just sounds better.
 24 hours for a missing persons report—can’t tell you how many people call 911 after their child/partner has been missing for that long.
24 hours for a missing persons report—can’t tell you how many people call 911 after their child/partner has been missing for that long.
 Referring to a post from a few minutes ago. You must drink 3 litres of water every day to maintain your health.
There is no scientific basis for this “fact” and overindulgence can be dangerous
Referring to a post from a few minutes ago. You must drink 3 litres of water every day to maintain your health.
There is no scientific basis for this “fact” and overindulgence can be dangerous
Drink when thirsty, if you are to thirsty go see medic it could be some issue. Food also contains water, that also needs to be counted in! Pee have no reason to be as translucent as the water from a natural spring.
 That Napolean was short. He was actually average height. The power of propaganda is immense.
That Napolean was short. He was actually average height. The power of propaganda is immense.
Seems some modern politicians are having issues with this too. Apparently a notorious far-right politician was recently spotted wearing high heeled boots to make himself look taller, even though he's a perfectly normal height at 5'8" without them.
Homeopathy
 That on average you swallow 8 spiders a year.
That on average you swallow 8 spiders a year.
 That if you touch a baby animal for any reason, their parents will abandon them because they now smell like you.
That if you touch a baby animal for any reason, their parents will abandon them because they now smell like you.
 That one anecdote that every paranoid snake-hater doles out about that pet python who stopped eating and would sleep in the bed with its owner. Supposedly "sizing her up" and "making room" to eat her.
Snakes aren't that smart. They're opportunistic predators, they don't really plan ahead. Could you imagine a python sliding up next to an antelope and calmly trying to compare measurements? Besides, the most common pet snakes are too small to eat a full grown human anyway. (They can definitely squeeze one to death on accident, so you should never handle a large snake alone, but they won't try to eat you afterwards.)
That one anecdote that every paranoid snake-hater doles out about that pet python who stopped eating and would sleep in the bed with its owner. Supposedly "sizing her up" and "making room" to eat her.
Snakes aren't that smart. They're opportunistic predators, they don't really plan ahead. Could you imagine a python sliding up next to an antelope and calmly trying to compare measurements? Besides, the most common pet snakes are too small to eat a full grown human anyway. (They can definitely squeeze one to death on accident, so you should never handle a large snake alone, but they won't try to eat you afterwards.)
 That you will make less by getting a raise due to getting into the next tax bracket (US specific). This is true only in very rare scenarios like receiving disability, but by and large, you won't make less per paycheck with a raise.
That you will make less by getting a raise due to getting into the next tax bracket (US specific). This is true only in very rare scenarios like receiving disability, but by and large, you won't make less per paycheck with a raise.
 Scientists don’t know how bees fly.
Scientists don’t know how bees fly.
It was a misunderstanding of a statement concerning fixed wing flight. Specifically that there's no way a bee could fly if it had wings like an airplane at that size. Which, yeah, no kidding.
 If you shave facial hair it grows back thicker
If you shave facial hair it grows back thicker
 That men have one less rib than women. I have no idea how people still spread this, but I heard it all throughout childhood
That men have one less rib than women. I have no idea how people still spread this, but I heard it all throughout childhood
Dang...now "I want my rib back" argument with my wife is null and void.
 Breakfast is the most important meal of the day
Breakfast is the most important meal of the day
That there are "left brain" and "right brain" people, at least the way people mean it.
Germans are completely hung up on the concept of only eating ONE hot meal a day. Other "facts": You do NOT stop being able to learn in old age, you do NOT benefit from drinking red wine (zero alcohol is the healthiest), you do NOT automatically gain weight after 30
As someone who went to college at 18 and then went back at 46 - brain elasticity changes over time and it is more difficult to retain new concepts and information
Oh come on BP Please! The last time this was done was only two days ago. Two Days!
At least they stopped the "Household Cleaning Supplies as Disney Princesses" or "Characters from The Office as Disney Princesses". And they haven't put up a terrible AI "art" thing in awhile. If they'd just stop with the tiktoks and the recycled c**p-on-America posts...
Load More Replies...I don't even need to read these anymore, they've been reposted so many times I have them seared in my memory. At this point just put it on the main page of BP permanently and save yourselves some time.
Oh come on BP Please! The last time this was done was only two days ago. Two Days!
At least they stopped the "Household Cleaning Supplies as Disney Princesses" or "Characters from The Office as Disney Princesses". And they haven't put up a terrible AI "art" thing in awhile. If they'd just stop with the tiktoks and the recycled c**p-on-America posts...
Load More Replies...I don't even need to read these anymore, they've been reposted so many times I have them seared in my memory. At this point just put it on the main page of BP permanently and save yourselves some time.

 Dark Mode
Dark Mode 

 No fees, cancel anytime
No fees, cancel anytime